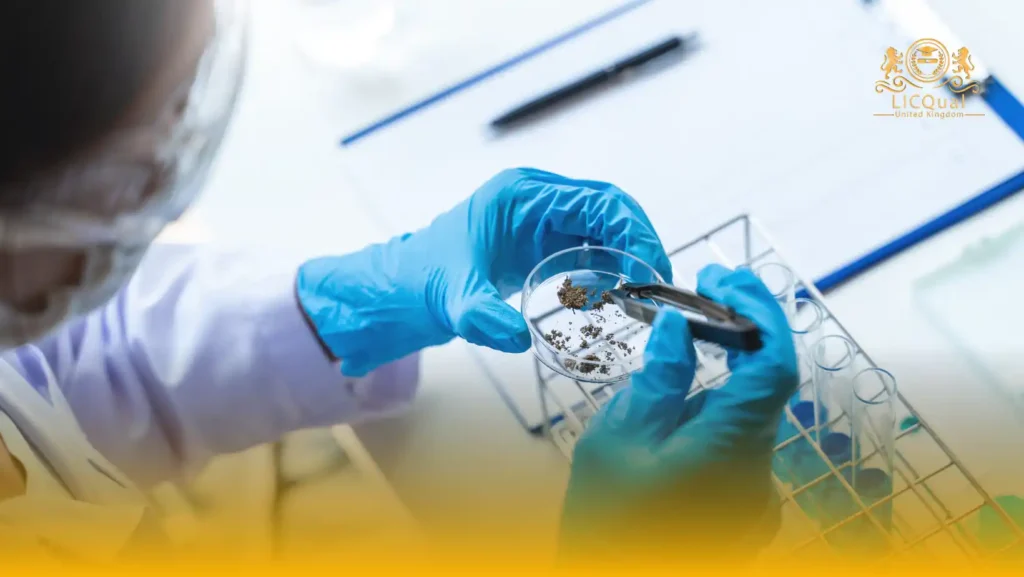

Pharmacy is a health science discipline that focuses on the discovery, preparation, dispensing, and proper use of medicines to improve patient health and well-being. It combines knowledge of biology, chemistry, and medicine to ensure that drugs are safe, effective, and of high quality.
Pharmacy professionals play a vital role in healthcare by advising patients on the correct use of medicines, monitoring their effects, and working alongside doctors and other healthcare providers to achieve the best therapeutic outcomes. The field of pharmacy extends beyond community and hospital practice into areas such as pharmaceutical research, drug manufacturing, clinical trials, and regulatory affairs, making it a diverse and essential profession in modern healthcare.